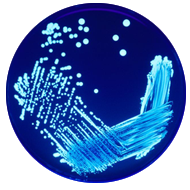

에어컨청소
- 에어컨은 세균의 천국으로 내부에 먼지가 축적될때까지 방치하기보단 정기적으로 전문 서비스를 받아야 합니다.
- 에어컨 세척으로 냄새와 세균을 제거하고 성능을 향상시키며 전기료를 절감할 수 있는 효과를 보실 수 있습니다.
이럴때 에어컨 청소를 을 추천합니다!
-
에어컨을 켜면 곰팡이 및 역겨운 냄새가 난다.
-
에어컨을 켜면 머리와 눈이 아프다.
-
전면커버를 열면 열교환기에 세균과 곰팡이로 오염되었다.
-
냉방능력 및 바람세기가 저하된다.
에어컨에서 발견되는 세균들
-
레지오넬라
레지오넬라 -
 클라도스포리움
클라도스포리움 -
 간상균
간상균 -
 살모넬라
살모넬라 -
 대장균
대장균 -
 진드기
진드기 -
 녹농균
녹농균 -
 곰팡이
곰팡이
